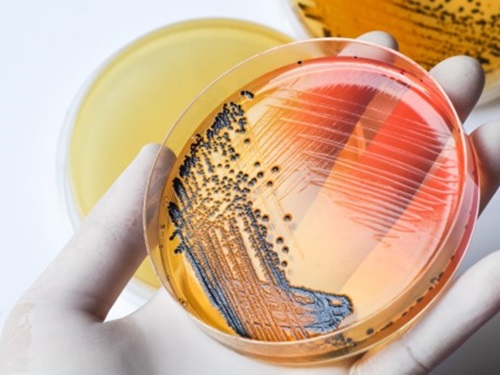

Ejecución Experimental de la Investigación
¿En qué consiste?
Asesoría al 100%.
- Certificado material de referencia
- Empleo de cepas microbianas
- Informe de resultados firmado
- Procedimiento de ensayo
- Uso de equipos calibrados
¿En qué te ayudamos?
Envíanos tus consultas. Nos encargaremos de comunicarnos para brindarte todo nuestro apoyo y nuestro mejor servicio.